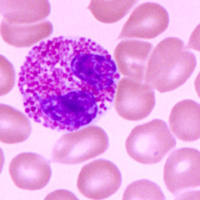
人肺MatchPair™:肺上皮细胞和肿瘤原代细胞【HumanLungMatchPair™

上海抚生实业有限公司品牌商
8 年
手机商铺
商家活跃:
产品热度:
- NaN
- 0
- 0
- 2
- 2
全部产品
- 查看全部分类
- 标准品
- 抗体
- ELISA试剂盒
- 小鼠elisa检测试剂盒
- 兔elisa检测试剂盒
- 豚鼠elisa检测试剂盒
- 人elisa检测试剂盒
- 羊elisa检测试剂盒
- 犬elisa检测试剂盒
- 猫elisa检测试剂盒
- 绵羊elisa检测试剂盒
- 马elisa检测试剂盒
- 牛elisa检测试剂盒
- 大鼠elisa检测试剂盒
- 鸡elisa检测试剂盒
- 其它elisa检测试剂盒
- ATCC细胞
- 菌种
- 标准品
- 化工产品
- 脂肪酸类
- 化学试剂
- 生化试剂
- 试剂盒
- Elisa检测试剂盒
- 细胞
- 对照品/标准品
- RNA/DNA提取
- 原代细胞
- 培养基
- PCR检测试剂盒
- 美国DRG试剂盒
- 科研抗体
- 生化检测试剂盒
- 科研抗体
- 进口品牌
- 常用标准
- 生物碱
- 黄酮
- 查尔酮
- 氧杂蒽酮
- 木脂素
- 香豆素
- 苯丙素
- 药物杂质及中间体
- 其它天然产物
- 蒽醌
- 其它醌类
- 甾体
- 二萜
- 其它萜类
- 环烯醚萜
- 倍半萜
- 其它酚类
- 三萜
- 进口检测试剂盒
- PCR试剂盒
- ELISA Kit
- 细胞生物学
- 耗材和仪器
- LAMP试剂盒
- 进口抗体
- FOR ELISA Kit
- PCR基因检测试剂盒
- 鉴定PCR试剂盒
- 进口PCR试剂
- B&I试剂盒
- 小分子试剂
- 细胞系
- 蛋白与多肽